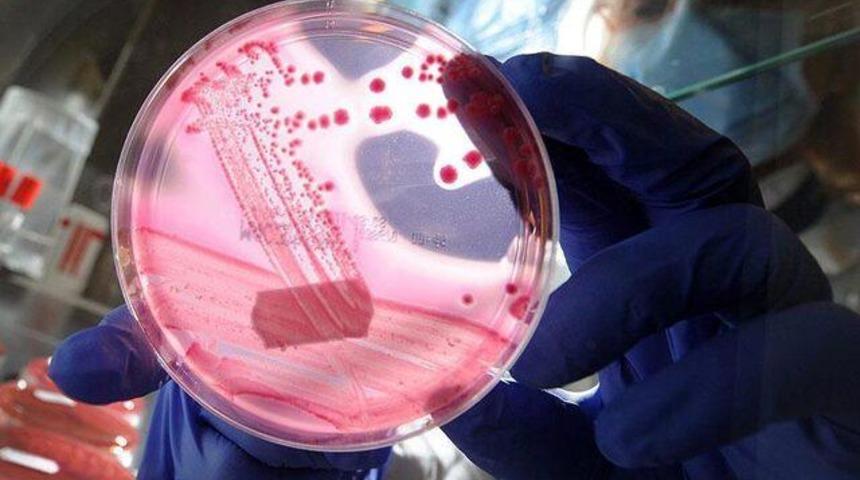
"Ben" kanser habercisi

Gaziosmanpaşa Üniversitesi (GOPÜ) Dermatoloji Anabilim Dalı Uzmanı Yard. Doç. Dr. Engin Sezer, özellikle sonradan oluşan ve büyüyen benlerin mutlaka bir doktora gösterilmesi gerektiğini ifade ederek, "Eğer benlerde aniden bir renk değişikliği oluyor ve büyüyor ise kanserden şüphelenmek gerekir" dedi.
Yard. Doç. Dr. Sezer, ozon tabakasındaki delinme ve insanların bronzlaşma alışkanlığındaki değişiklikleri ile birlikte son yıllarda cilt kanseri görülme oranının arttığına dikkat çekerek, "Deri kanserine neden olabilecek benlerin erken tanı ve tedavisi bu durumda önem kazanmaktadır. Dermatologlar tarafından kullanılan Dermatoskop isimli cihazla risk taşıyan benlerin tanısı kolaylaşmaktadır" diye konuştu.
Yard. Doç. Dr. Sezer, insanların 11.00 ile 14.00 saatleri arasında bronzlaşmaktan kaçınması gerektiğini vurgulayarak, boyut görünümü olarak değişkenlik gösteren benlerin mutlaka muayene edilmesi gerektiğini de
sözlerine ekledi.